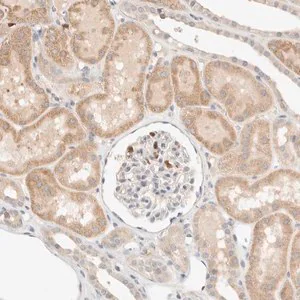
Merck Anti-TTC3 antibody produced in rabbit

Merck Anti-TTC3 antibody produced in rabbit
Merck의 Anti-TTC3 rabbit antibody는 Down syndrome critical region 관련 단백질을 표적하는 고품질 항체입니다. Atlas Antibodies 기술 기반 Prestige Antibody로 높은 특이성과 재현성을 제공합니다. E3 유비퀴틴 리가아제 TTC3 단백질 검출에 적합합니다.
✨AI 추천 연관 상품
AI가 분석한 이 상품과 연관된 추천 상품들을 확인해보세요
연관 상품을 찾고 있습니다...
Anti-TTC3 antibody produced in rabbit
Prestige Antibodies® Powered by Atlas Antibodies
Affinity isolated antibody, buffered aqueous glycerol solution, Ab2
Target Information
Anti-Tetratricopeptide repeat protein 3 (TTC3)
Also known as:
- Anti-Protein DCRR1
- Anti-RING finger protein 105
- Anti-TPR repeat protein D
- Anti-TPR repeat protein 3
TTC3 (tetratricopeptide repeat protein 3) is one of the main genes present within the Down syndrome critical region (DSCR) on human chromosome 21q22.2.
The encoded protein is an E3 ubiquitin ligase composed of 2025 amino acids.
Its N-terminal region contains three tetratricopeptide repeat (TPR) motifs, a RING (really interesting new gene) finger motif, a putative Akt phosphorylation site, and nuclear localization signals.
제품 스펙
| 항목 | 내용 |
|---|---|
| 제품명 | Anti-TTC3 antibody produced in rabbit |
| 브랜드 | Prestige Antibodies® Powered by Atlas Antibodies |
| 공급업체 | Merck Sigma |
| 대상 단백질 | Tetratricopeptide repeat protein 3 (TTC3) |
| 동의어 | Protein DCRR1, RING finger protein 105, TPR repeat protein D, TPR repeat protein 3 |
| 형식 | Affinity isolated antibody |
| 용액 | Buffered aqueous glycerol solution |
| 종 | Rabbit |
| 기능 | TTC3 단백질 검출 및 연구용 |
| 관련 유전자 위치 | Human chromosome 21q22.2 (Down syndrome critical region) |
🏷️Merck Sigma 상품 둘러보기
동일 브랜드의 다른 상품들을 확인해보세요

Merck Sigma
Merck Anti-TMEM245 antibody produced in rabbit
895,700원

Merck Sigma
Merck Anti-RUNDC1 antibody produced in rabbit
951,160원

Merck Sigma
Merck Anti-TTC3 antibody produced in rabbit
895,700원

Merck Sigma
Merck Anti-ZFP91 antibody produced in rabbit
895,700원

Merck Sigma
Merck Anti-RNF26 antibody produced in rabbit
370,530원
배송/결제/교환/반품 안내
배송 정보
| 기본 배송비 |
| 교환/반품 배송비 |
|
|---|---|---|---|
| 착불 배송비 |
| ||
| 교환/반품 배송비 |
| ||
결제 및 환불 안내
| 결제수단 |
|
|---|---|
| 취소 |
|
| 반품 |
|
| 환급 |
|
교환 및 반품 접수
| 교환 및 반품 접수 기한 |
|
|---|---|
| 교환 및 반품 접수가 가능한 경우 |
|
| 교환 및 반품 접수가 불가능한 경우 |
|
교환 및 반품 신청
| 교환 절차 |
|
|---|---|
| 반품 절차 |
|